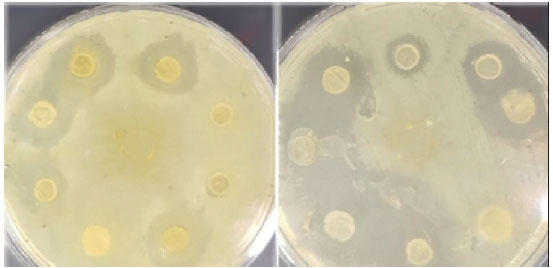

ケフィアライフをお勧めする中垣技術士事務所

| 文献調査(植物性ヨーグルト、プランタルム菌の科学:研究の最前線) |
Lactobacillus Plantarumとその派生バクテリオシンは 食道がん細胞に対して強力な抗腫瘍活性を示す |
Salam Husam Sabri et al., |
|
|
| 要約 |
食道がんは消化器科における課題であり、従来の化学療法や放射線療法は治療効果が低く、副作用が重篤です。そのため、効果的でより安全な代替療法が必要です。プロバイオティクス、特にLactobacillus plantarum (L. plantarum) とそのバクテリオシンは、食道腫瘍を予防または治療する可能性があります。私たちは、L. plantarum とそのバクテリオシンを食道がん治療に使用することを調査することを目的としました。まず、乳製品サンプルからLactobacillus 属の分離株 100 株を入手しました。バクテリオシン産生をスクリーニングし、PCR とゲル電気泳動によって 16S リボソーム RNA 遺伝子を同定しました。バクテリオシンは部分的に精製され、2 つの異なる病原体に対してテストされました。 L. plantarum とそのバクテリオシンの両方について、MTT アッセイにより食道がん細胞株 (SK-GT4) と正常ラット胎児線維芽細胞 (REF) に対する細胞毒性を in vitro で検査しました。アポトーシスはアクリジンオレンジ / プロピジウムヨウ化物アッセイを使用して決定しました。結果から、分離株は約 2000 AU/ml の高いバクテリオシン産生をもたらすことが示されました。抗菌活性に加えて、顕著な抗がん活性がありました。がん細胞に対する L. plantarum の IC50 は 51.01 CFU/ml、バクテリオシンの IC50 は 281.9 AU/ml でした。どちらも正常ラット胎児線維芽細胞細胞に対する細胞毒性を示さなかった。さらに、L. plantarum とバクテリオシンで処理したがん細胞では、未処理細胞と比較してアポトーシス誘導とカスパーゼ 3 活性が大幅に増加しました。結論として、L. plantarum とそのバクテリオシンは、食道がん細胞に対して強力な殺傷効果を示し、正常細胞には影響を及ぼさないことから、安全性と選択性を示し、カスパーゼ 3 誘導によるアポトーシスの活性化は潜在的な臨床的利点を示唆しています。 |
| 目次(クリックして記事にアクセスできます) |
| 1.はじめに |
| 2.材料と方法 |
| 2.1.細菌分離株 |
| 2.2. Lactobacillus 分離株の識別 |
| 2.2.1.カタラーゼ試験 |
| 2.2.2.オキシダーゼ試験 |
| 2.2.3. Lactobacillus 分離株のスクリーニングによるバクテリオシン生産 |
| 2.2.4.PCR による L. plantarum の遺伝子同定 |
| 2.3.バクテリオシンの精製 |
| 2.3.1硫酸アンモニウムによる沈殿 |
| 2.3.2セファデックスゲルろ過 |
| 2.4.試験管内抗菌性の可能性の評価 |
| 2.4.1.ウェル拡散アッセイ |
| 2.4.2バクテリオシン活性の測定 |
| 2.5. Lactobacillus plantarumとそのバクテリオシンの抗がん効果の特定 |
| 2.5.1. Lactobacillus plantarum製品 (バクテリオシン) の調製 |
| 2.5.2.食道がん細胞株の維持 |
| 2.5.3.MTT アッセイ |
| 2.5.4.アポトーシスアッセイ |
| 2.5.5.アクリジンオレンジ/ヨウ化プロピジウムによる蛍光アッセイ |
| 3.結果 |
| 3.1生化学検査 |
| 3.2.L. plantarum とそのバクテリオシンの食道がん細胞に対する細胞毒性および細胞増殖効果 |
| 3.3.処理した細胞のアポトーシス指標としてのカスパーゼ 3 活性 |
| 3.4アクリジンオレンジとヨウ化プロピジウム染色 |
| 4.考察 |
本文 |
| 1.はじめに |
| 食道がんを含む消化管の腫瘍は、ヒトの悪性腫瘍の中で最も一般的な種類のがんの 1 つであり (1)、世界中のがん関連死亡の約 15% を占め、食道がんは世界で 6 番目に多い種類のがんであると考えられていることを考えると、がんは世界中で主要な死亡原因の 1 つです (1)。一方、消化管がんは、複雑な障害と異質な疾患のグループであり (2)、消化管がんの発生率は急速に増加しています (3)。環境的および遺伝的リスク要因が組み合わさって、正常組織が前がん病変に変化し、悪性細胞につながる可能性があります (2)。がん治療の進歩にもかかわらず、化学療法と放射線療法に対する耐性の発現は、特に栄養補助食品として使用されるさまざまなプロバイオティクス株による消化管腫瘍の新しい診断および治療法の開発の進歩に関連して、依然として大きな課題です。そのため、プロバイオティクスを抗がん治療薬として使用することは、近年大きな注目を集めています。さまざまな環境に生息する多くの細菌は、他の細菌に対して有効な抗がん物質や抗菌物質を生成します (4)。抗菌ペプチドは、さまざまな細菌によって生成される他の種類の細菌の増殖を阻害することができます (5)。抗菌ペプチドは、生合成経路によってリボソームペプチドと非リボソームペプチドに分類できます。リボソーム合成された抗菌ペプチドはバクテリオシンとして知られています (6)。 |
| Lactobacillus 属は、強力な抗菌作用を持つことが証明されているプロバイオティクス細菌のグループです。直接的な抗がん作用に加えて、Lactobacillus 属はバクテリオシンも生成します。バクテリオシンは抗菌ペプチドで、病原菌の増殖を抑制し、がんの発症を予防する可能性があります (6)。Lactobacillus の効力は、純粋なバクテリオシン製品とともに食道がんに適用されました。食道がんは、喉と胃をつなぐ管である食道に影響を与えるがんの一種です。研究では、Lactobacillus ががん細胞の増殖を抑制し、食道の炎症を軽減することで、食道がんの発症を予防できることが示されています (7)。全体として、この目的は、将来の臨床応用の可能性を探るために、in vitro での抗食道がん療法としての L. plantarum とそのバクテリオシンの使用を調査することです。 |
| 2.材料と方法 |
| 2.1.細菌分離株 |
| L. plantarum 分離株は、2022 年 1 月から 2022 年 3 月の間に乳製品から収集された 100 サンプルから選択されました。全体として、自家製ヨーグルトからの乳酸菌の分離は、牛乳を 30 分間沸騰させてから 40℃に冷却することによって行われました。古いヨーグルトを追加し、容器をカバーして室温で 12 時間保存しました。この自家製ヨーグルト 1 gを 10 ml の生理食塩水に追加し、10-1 - 10-7 の連続希釈液を調製しました。次に、最後の 3 つの希釈液から 100 µL を MRS 寒天培地のプレートに塗布し、嫌気性ジャーで 37 ℃ で 24 ~ 48 時間培養しました。その後、pH 6 の MRS 寒天培地に接種し、37 °C で 24 時間培養しました。その後、嫌気性ジャーで 37 °C の MRS 寒天培地に 48 時間接種しました。その後、MRS 寒天培地から単一コロニーを取り出し、同じ条件下で別の MRS 寒天培地プレートで培養しました。細菌分離株は、Bergey の系統的細菌学マニュアル (8) に記載されている生化学検査と培養特性を使用して同定しました。 |
| 2.2. Lactobacillus 分離株の識別 |
| 2.2.1.カタラーゼ試験 |
| この試験では、きれいなスライド上の単一の細菌コロニーに 3% H2O2 を数滴加えます。気泡の生成は細菌がカタラーゼ酵素を生成する能力があることを示し、陽性の結果をもたらします。 |
| 2.2.2.オキシダーゼ試験 |
| 細菌のコロニーを 1 つ採取し、オキシダーゼ試薬で湿らせたろ紙に塗りつけます。数秒以内に濃い紫色が現れると陽性反応が示されます (9)。 |
| 2.2.3. Lactobacillus 分離株のスクリーニングによるバクテリオシン生産 |
| Lactobacillus 分離株をスクリーニングし、バクテリオシンを生産するものを選択しました。2 つの分離株を指標として使用し、バクテリオシンの生産を検出しました (Pseudomonas aeruginosa (P. aeruginosa) とEscherichia coli (E. coli)。スクリーニング法では、Abd と Luti (10) によって説明されているウェル拡散法を使用しました。ウェルの周囲の阻止帯は、各分離株の抗菌活性を決定するための尺度として使用されました (11)。 |
| 2.2.4.PCR による L. plantarum の遺伝子同定 |
| 細菌 DNA は、製造元のプロトコルに従って、Geneaid「presto」(韓国) キットを使用して抽出されました。精製された DNA は TE バッファーで 1:100 の割合で希釈され、分光光度計を使用して波長 260 nm での吸光度を測定して濃度と純度が測定されました。PCR には、L. plantarum の 16S リボソーム RNA 遺伝子に特異的なプライマーが使用されました。(12)。 |
| PCR 用のマスターミックス (凍結乾燥) (反応要件の最適濃度 (MgCl 2 1.5 mM、Taq ポリメラーゼ 1 U、各 dNTP 200 μM) を含む) を 12.5 μl 取り、細菌 (3 μl) と、設計プライマー (TGGAAACAGRTGCTAATACCG) およびリバース (GTCCATTGTGGAAGATTCCC) からそれぞれ 1 μl を混合し、その後、会社の指示に従って遊離ヌクレアーゼ d.dH2O で 25 μl まで容量を補充しました。これは Lactobacillus plantarum と識別され、本研究で使用されました。 |
| 2.3.バクテリオシンの精製 |
| 2.3.1.硫酸アンモニウムによる沈殿 |
| バクテリオシンは、異なる飽和レベルの硫酸アンモニウム (20、30、40、50、60、70、80、90%) を使用して沈殿させることにより精製されました。硫酸アンモニウムは、4 °C で穏やかに撹拌しながら、細胞を含まない上清 (CSF) にゆっくりと加えられました。その後、沈殿物は 10000 rpm で 30 分間遠心分離して分離されました。得られた沈殿物は、pH 7.2 の適切な量の 0.1M リン酸緩衝液に再溶解されました。溶解した沈殿物は、1 kDa MW カットオフの透析膜チューブを使用して、リン酸緩衝液で個別に透析されました。沈殿物を含む透析バッグは、4 °C で一晩 0.5 L のリン酸緩衝液に入れられ、緩衝液は 4 回交換されました。次に、透析したタンパク質の抗菌活性を、P. aeruginosa とE. coli を指標菌株として寒天ウェル拡散試験で測定した(11、13S)。 |
| 2.3.2.セファデックスゲルろ過 |
| 実験で得られたバクテリオシンをセファデックス G-50 ゲル濾過カラム (1.6 × 90 cm) にロードした。 タンパク質の溶出は、リン酸緩衝液 (0.1 M、pH 7) を使用して流速 36 ml/時間で行い、3 ml の画分を収集した。 合計 117 の画分を収集し、それらの吸光度を 280 nm で測定した。 P. aeruginosa および E. coli に対する抗菌活性は、ウェル寒天拡散アッセイを使用してテストした。 抗菌活性を示す画分を 1 つのチューブに混合し、タンパク質の濃度をバクテリオシン活性 (11、13S) とともに Bradford 法を使用して測定した。 |
| 2.4.試験管内抗菌性の可能性の評価 |
| 2.4.1.ウェル拡散アッセイ |
| 分離株におけるバクテリオシンの産生は、ウェル拡散アッセイを使用して評価しました。ユニバーサル チューブに一晩培養した分離培養物の 2% を接種し、37°C で 48 時間培養した後、チューブを 10000 rpm で 15 分間遠心分離して細胞を含まない上清を取得し、滅菌状態で濾過しました。有機酸と H2O2 活性の影響を中和するために、NaOH とカタラーゼ溶液を上清に加えました。その後、寒天ウェル拡散アッセイを使用して、各分離株の上清のバクテリオシンを検査しました。このアッセイでは、指標細菌の一晩培養培養物 100 μL を滅菌 Muller Hinton 寒天 (MHA) 25 mL と混合し、混合物を滅菌プラスチックペトリ皿に注ぎました。直径 5mm の円形ウェルを切り取り、低融点 MHA で密封しました。次に、ろ過した上清 100 μL をウェルに散布し、プレートを 37 °C で 24 時間培養しました。各ウェルの周囲の成長阻害ゾーンの直径を測定して、バクテリオシン活性を測定しました。 |
| 2.4.2.バクテリオシン活性の測定 |
| バクテリオシン活性は、抗生物質の評価に使用される最小発育阻止濃度法 (MIC) に類似した臨界希釈法を使用して評価されました。この方法では、Lactobacillus培養物の一連の 2 倍希釈液を準備します。次に、この培養物に一晩培養した分離株の 2% を接種し、37°C で 24 時間培養します。培養後、培養液を 10,000 回転/分 (rpm) で 15 分間遠心分離し、細胞を含まない上清を収集します。次に、上清を滅菌条件下で 0.22 μm ミリポア フィルター ペーパーを使用してろ過します。有機酸と H2O2 活性の影響を中和するために、NaOH とカタラーゼ溶液を添加し、有機酸と H2O2 活性の影響を中和しました。一連のエッペンドルフチューブを準備し、それぞれに滅菌リン酸緩衝液 500μl を入れました。最初の 2 倍希釈にはLactobacillus培養液 500μL を使用し、次に 2 倍希釈を行いました。次に、細胞を含まない上清希釈液を分析し、寒天ウェル拡散アッセイを使用してバクテリオシンの存在を検出しました。バクテリオシンの活性は、任意単位 (AU) で測定され、特定の方程式を使用して決定されました。 |
| 2.5. Lactobacillus plantarumとそのバクテリオシンの抗がん効果の特定 |
| 2.5.1. Lactobacillus plantarum製品 (バクテリオシン) の調製 |
| 100 ミリリットルの MRS ブロス培地に 108 CFU / mL の L. plantarumを接種し、5% CO2 で 37 ° C で 48 時間培養しました。培養後、成長培養物を 0.45 マイクロメートルの孔径を持つミリポア フィルターを使用して濾過しました。その後、4 °C で異なる飽和レベル (20、30、40、50、60、70、80、90) % の硫酸アンモニウム沈殿による部分精製を行い、その後 10000 rpm の速度で 30 分間遠心分離して分離しました。その後、沈殿物を適切な量の pH 7 の 0.1M リン酸緩衝液に溶解し、透析膜チューブ (3500 kDa MW カットオフ) とセファデックスゲルろ過クロマトグラフィー法を使用して 0.5 リットルのリン酸緩衝液で 4 °C で一晩透析し、バクテリオシンをセファデックス G-50 ゲルろ過の 1.6×90 cm カラムにロードしました。溶出は、pH 7.2 の 0.1 M リン酸緩衝液を使用して 36 ml/時の流速で実行され、280 nm での吸光度を測定するために各チューブに 3 mL の画分が収集されました。最後に、抽出物は使用するまで -20 °C で保存されました |
| 2.5.2.食道がん(SK-GT4)細胞株の維持 |
| 細胞培養は、10% リン酸緩衝液を含む RPMI-1640(Elabscience, China)および DMEM 培地(Elabscience, China)で維持されました。細胞は 37°C、5% CO2 で培養され、3 ~ 4 日ごとに継代されました。細胞の継代培養中は、培地を廃棄し、75 ml フラスコにトリプシン-EDTA 溶液 3 ml を加えました。次に、フラスコをインキュベーターに戻し、3 分間培養しました。細胞溶液をピペットで採取して塊を単一細胞に分離し、新鮮な培地を加えて細胞懸濁液の 4 分の 1 の量を維持しました。 |
| 2.5.3.MTT アッセイ |
| 異なる濃度 (2000、1000、500、250、125、62.5、31.25、15.62 AU/mL) のバクテリオシンと 5 つの濃度 (100、50、25、12.5、6.25 CFU/mL) の L. plantarum の細胞増殖と細胞毒性効果を、MTT 細胞増殖および細胞毒性アッセイ キットを使用して測定しました。簡単に説明すると、104 個の細胞を 96 ウェル プレートに播種し、プレート表面に接着するように 37°C で 72 時間インキュベートしました。インキュベーション後、各濃度のバクテリオシン 100 µg/mL をウェルに加え、細胞を 72 時間培養しました。インキュベーション期間後、培地を除去し、Elabscience, Chinaのジメチルスルホキシド溶液(DMSO)150μLを各ウェルに加えて、MTT溶液キット(Elabscience, China)を溶解しました。その後、製造元のプロトコルに従って、マイクロプレートリーダーを使用して、各ウェルの吸光度を波長570 nmで測定しました。 |
| 2.5.4.アポトーシスアッセイ |
| 食道がん細胞におけるカスパーゼ 3 活性またはバクテリオシンのさまざまな濃度での潜在的なアポトーシスを検出するアポトーシスアッセイには、カスパーゼ 3 活性アッセイ キットを使用しました。付着細胞はトリプシンで剥離し、沈降細胞を収集します。細胞を 2000 rpm で 5 分間遠心分離した後、上清を捨ててリン酸緩衝液で穏やかに再懸濁します。再度 2000 rpm で 5 分間遠心分離し、上清を捨てます。次に、2×106 個の細胞ごとに 50 μL の冷溶解バッファー作業溶液を加えて再懸濁します。氷浴で 30 分間インキュベートし、インキュベーション中に 4 回振動させてテストします。アポトーシスの可能性を調べるために、カスパーゼ 3 活性アッセイ キット (Elabscience, China) を使用しました。Ac-DEVD-pNA と 2× 反応バッファーを溶解して氷上に置きました。反応作業溶液の調製には、50 μL の 2× 反応バッファーごとに 0.5 μL DTT が含まれます。細胞溶解物または組織ホモゲネート上清 (100~200 μg のタンパク質を含む) を 45 μL の細胞溶解物に加えます。反応は特定の計算によって決定されました。 |
 |
| 2.5.5.アクリジンオレンジ/ヨウ化プロピジウムによる蛍光アッセイ |
| 選択された癌細胞株は、MTT アッセイから得られた IC50 濃度で処理されました。細胞は 1 mg/mL のアクリジンオレンジ (AO) とヨウ化プロピジウム (PI) で染色され、その後蛍光顕微鏡を使用して観察され、アクリジンオレンジ/ヨウ化プロピジウム蛍光アッセイが行われました。 |
| 3.結果 |
| MRS 寒天培地で増殖したLactobacillus コロニーの形態学的特徴は、グラム陽性、3~8 個の細胞を持つ桿菌で、まれにしか発生せず、胞子を形成せず、運動性がなく、短鎖および長鎖のクラスターを形成することです (図 1 を参照)。 |
 |
| 図1 顕微鏡下の乳酸菌細胞。最初の画像は染色なし、2 番目の画像はグラム染色済み |
| 3.1.生化学検査 |
| 本研究で使用した分離株を特定するために、いくつかの生化学検査を実施しました。結果から、分離株はカタラーゼとオキシダーゼに対して陰性であり、過酸化水素を変換する酵素を生成できないことがわかりました。さらに、ウェル拡散寒天法を使用して各分離株の抗菌活性を評価し、阻止円直径が最も大きい分離株を本研究で使用するために選択しました (図 2 および 3)。 |
|
| 図 2. ウェル拡散法を用いて Lactobacillus 分離株を一次スクリーニングし、P. aeruginosa および E.coli 指標に対するバクテリオシン産生を検出します。 |
 |
| 図3 ウェル拡散法を用いて2つの指標(P. aeruginosa および E.coli)に対するバクテリオシン産生を検出する二次スクリーニング。 |
| 最も高いバクテリオシン生産量 (2000AU/ml) を示したLactobacillus分離株は、16S リボソーム RNA 遺伝子を使用した分子検出によってさらに特定されました。PCR 増幅とアガロースゲル電気泳動の結果、長さ約 231 bp の DNA 断片が L. plantarum に属し、99.57% の類似性があることが明らかになりました (図 4)。 |
 |
| 図 4. Lactobacillus 株の 16S rRNA にコードされている遺伝子の 4 つの異なる分離株 (1、2、3、4) の増幅のゲル電気泳動。電気泳動は 1% アガロースゲルで実施し、5v/cm の電流で 1.5 時間泳動しました。(1500bp) ラダー (M) 付き。 |
| バクテリオシンは、硫酸アンモニウム沈殿とその後のセファデックス G-50 ゲル濾過による分離によって部分的に精製されました。図 5 に示すように、部分的に精製されたバクテリオシンの比活性は 2000 AU/mg に増加しました。 |
 |
| 図5. Lactobacillus属菌が産生するバクテリオシンの精製は、セファデックスG-50カラム(1.6×90cm)を使用して実施しました。カラムは平衡化され、pH7のリン酸ナトリウム緩衝液で流速0.6ml/分で溶出されました。 |
| 3.2.L. plantarum とそのバクテリオシンの食道がん細胞に対する細胞毒性および細胞増殖効果 |
| L. plantarum 細胞増殖とそのバクテリオシンの細胞毒性は、MTT アッセイを使用して評価されました。したがって、6.25、12.5、25、50、および 100 CFU/mL の濃度の L. plantarum で処理した食道がん細胞は、72 時間の培養で細胞増殖の中程度の阻害を示しました。図 (6、7) に示すように、72 時間の培養で 100 CFU/mL の濃度の場合、細胞毒性阻害率はそれぞれ 96.45%、84.49%、71.87%、53.43%、および 39.89% でした。 |
 |
| 図 6. 食道がん細胞における MTT 分析。食道がん細胞株を、L. plantarum のさまざまな濃度で 72 時間処理しました。 |
 |
| 図 7. 細菌 (Lactobacillus plantarum) 処理前後の 食道がん細胞。A) 濃度 100 CFU/ml の L. plantarum。B) 濃度 50 CFU/ml のL. plantarum。C) 濃度 25 CFU/ml のL. plantarum。D) 未処理のコントロール 食道がん。 |
| 15.62 AU/mL、31.25 AU/mL、62.5 AU/mL、125 AU/mL、250 AU/mL、500 AU/mL、1000 AU/mL、2000 AU/mLの濃度のバクテリオシンで処理した食道がん細胞は、72時間の培養で細胞増殖の高い阻害を示した。さらに、図(8、9)に示すように、72時間の培養で2000 AU/mlの濃度で細胞毒性の阻害率はそれぞれ96.06%、93.26%、91.46%、83.29%、74.80%、66.82%、52.81%、41.10%であった。 |
 |
| 図 8.食道がん細胞における MTT 分析。食道がん細胞株を、72 時間の時点で L. plantarum 由来のバクテリオシンのさまざまな濃度で処理しました。 |
 |
| 図 9. バクテリオシン処理前後の 食道がん細胞 A) 濃度 2000 AU/mL のバクテリオシン。B) 濃度 500 AU/mL のバクテリオシン。C) 濃度 125 AU/mL のバクテリオシン。D) 未処理のコントロール食道がん細胞。 |
| これらの結果によると、L. plantarum の最も強い効果は 100 CFU/ml の濃度で見られ、バクテリオシンは 72 時間の培養で 2000 AU/ml の濃度で見られました。 |
| さらに、図 10 と 11 に示すように、各細胞生存率の濃度の関係に基づいて、L. plantarum とバクテリオシンの IC50 値が計算されました。計算された L. plantarum の IC50 値は 51.01 CFU/ml に相当し、バクテリオシンは 281.9 AU/ml に相当しました。これらの値は、細胞生存率を 50% 阻害するために必要なサンプル濃度 (µg/mL) を示します。結果は、バクテリオシンの IC50 値が L. plantarum の値よりも大幅に高いことを示しました。これにより、バクテリオシンは L. plantarum よりも 食道がん細胞に対して優れた阻害活性を持つことが確認されました。さらに、バクテリオシンのタンパク質化合物は、阻害特性の原因となる生理活性化合物の 1 つであると想定されました。 |
 |
| 図 10. L. plantarum による食道がん細胞株の IC50 値と阻害曲線。食道がん細胞株の成長曲線と L. plantarum の IC50値の相関関係を示す曲線。データは、少なくとも 3 つの独立した実験の平均 ± SEMとして表されます。 |
 |
| 図 11. 食道がん細胞株におけるバクテリオシンの IC50 値と阻害曲線。食道がん細胞株の成長曲線とバクテリオシンの IC50 値の相関を示す曲線。データは、少なくとも 3 つの独立した実験の平均 ± SEM として表されます。食道がん細胞における L. plantarum とそのバクテリオシンの IC50 値。 |
| したがって、IC50 値は勾配方程式を使用して計算されました。値は、約 50% の阻害をもたらすために必要な濃度を示しています。細胞毒性 IC50 は、L.plantarum で処理した細胞 (51.01 CFU/mL) で最も低く、バクテリオシンで処理した細胞では、281.9 AU/ml の IC50 値が、このテストで最も強力な阻害剤であることが示されました。 |
| 3.3.処理した細胞のアポトーシス指標としてのカスパーゼ 3 活性 |
| カスパーゼ 3 の発現は、L. plantarum で処理した 食道がん細胞株では未処理の 食道がん細胞コントロールと比較して有意に高く (それぞれ p = 0.1、p = 0.8)、L. plantarum で処理した 正常細胞株では正常細胞コントロールと比較して有意に高く (それぞれ p = 1.15、p = 0.9) なりました (図 12 参照)。食道がん細胞を L. plantarum で処理すると、アポトーシス細胞の割合が大幅に増加しました。今回の研究では、L. plantarum 処理によるカスパーゼ 3 の活性化とアポトーシスの発生を観察しました。 |
 |
| 図 12. カスパーゼ-3活性の分析。未処理細胞と処理細胞におけるアポトーシス細胞の割合を比較。正常細胞 は L. plantarum で処理され、食道がん細胞も L. plantarum で処理されました。細胞は処理され、その後カスパーゼ 3 分析を使用して評価されました。 |
| 図 13 に示すように、バクテリオシン処理した 食道がん細胞株では 食道がん細胞コントロールと比較してカスパーゼ 3 の発現が有意に高く (それぞれ p = 0.25、p = 0.80)、バクテリオシン処理した正常細胞株では 斉唱細胞コントロールと比較してカスパーゼ 3 の発現が有意に高く (それぞれ p = 0.98、p = 0.9) なりました。食道がん細胞をバクテリオシンで処理すると、アポトーシス細胞の割合が大幅に増加しました。この研究では、バクテリオシン誘発性のカスパーゼ 3 活性化とアポトーシスが観察され、L. plantarum 製品誘発性のアポトーシス応答のさらなる証拠が得られました。これらの結果は、バクテリオシンが正常細胞を傷つけることなくがん細胞を大幅に殺すことを裏付けています。 L. plantarum に関しては、アポトーシスにおいて癌細胞を選択し、カスパーゼ 3 を介してそれらを除去するため、カスパーゼ 3 特異的アポトーシスに対して大きな効果があり効果的です。したがって、これらの結果は、バクテリオシンが食道がん細胞株に対して高い毒性を示し、L. plantarum がカスパーゼ 3 アポトーシスの高指標であることを確認しています。 |
 |
| 図 13. カスパーゼ 3 分析を実施し、バクテリオシン処理した未処理の正常細胞と 食道がん細胞におけるアポトーシス細胞の割合を判定しました。食道がん細胞はバクテリオシンで処理しました。細胞は処理され、カスパーゼ 3 分析によって評価されました。 |
| 3.4.アクリジンオレンジとヨウ化プロピジウム染色 |
| L. plantarum による 食道がん細胞での細胞死は、標準的な手順に従い、アクリジンオレンジ (AO) とヨウ化プロピジウム (PI) 染色を使用して定量化され、蛍光顕微鏡 (q-floro ソフトウェアが付属した Leica DM IRB) (Wetzlar, Germany) で検査されました。 |
| 形態学的変化の研究に加えて、食道がん細胞におけるアクリジンオレンジ (AO) およびプロピジウムヨウ化物 (PI) 染色を使用してアポトーシス細胞を解析しました。細胞は L. plantarum およびそのバクテリオシンで処理されました。図 14A および 14B に示すように、蛍光顕微鏡を使用してバクテリオシン誘発細胞死の形態学的変化を研究しました。 |
 |
| 図 14。A) 画像はアポトーシスの実験を表しています。食道がん細胞株の蛍光顕微鏡検査 (倍率 400 倍)。バクテリオシンで処理した食道がん細胞。B) L. plantarum で処理した 食道がん細胞の蛍光顕微鏡検査。C) L. plantarum とバクテリオシンで処理した 食道がん細胞で、アクリジン オレンジ (AO) とプロピジウム ヨウ化物 (PI) 染色を使用してアポトーシス細胞を数えました。 |
| アクリジンオレンジ (AO) とヨウ化プロピジウム (PI) 染色を使用して、生存細胞とアポトーシス細胞を区別しました。生存細胞は緑色の蛍光で識別され、丸く無傷の核と無傷の DNA を持っていました。対照的に、アポトーシス細胞は断片化された DNA を示し、赤く染色されました (図 14C)。 |
| 4.考察 |
| 本研究では、L. plantarum とそのバクテリオシンが食道がん細胞に及ぼす細胞毒性とアポトーシス効果を調査し、将来のがん治療に活用するための貴重な知見を提供しました。L. plantarum とバクテリオシンはどちらも、がん細胞に対する抗がん作用と、正常な哺乳類細胞に対する低い細胞毒性を持つことがわかりました。さまざまな研究がプロバイオティクスの有益な効果に焦点を当てており、この結果はがん細胞の生存率と腫瘍サイズの減少で十分に実証されており、Adiyoga と彼のグループによる以前の研究で示された結果と一致しています。 |
| 本研究では、自家製ヨーグルトのサンプル 100 個から分離された L. plantarum を、主に食道がん細胞に対する抗菌作用と抗がん作用を目的とした有益な特性を持つバクテリオシンと呼ばれる代謝産物の活性を中心に特徴づけました。 |
| 同様に、(11,15)は、形態学的特徴として、MRS寒天培地上で増殖したLactobacillusのコロニーはグラム陽性(G + ve)で、約3〜8個の細胞を含むクラスター鎖を形成し、まれに単一の細胞を含む桿菌のように見えること、また胞子を形成せず運動性もないことを示しており、これらの結果は以前の研究者によって記録されたものと一致しています。 |
| (16,17)によると、結果は、分離株がカタラーゼ酵素を生成できないため、カタラーゼ試験が陰性であることを示しており、カタラーゼ酵素は過酸化水素を水と酸素ガス泡に変換する役割を果たしています。さらに、分離株はテトラメチルフェニレンジアミンの酸化を担うシトクロムオキシダーゼを生成できないため、オキシダーゼ試験は陰性の結果が得られました。これらの結果は私たちの研究と一致していました。さらに、結果は、この研究で特徴付けられたバクテリオシンが20°Cから100°Cの広い範囲の温度に対して非常に安定していることを示しました。また、同様に、(18)で生成されたL. plantarum LPL-1は、広いpH安定性(2〜10)と高い熱安定性(121°C、20分)を示しました。さらに、(11、19)によると、PCR分析を用いて分子診断が行われ、診断が確認され、遺伝子分析によりlactobacilli.の分類が進歩しました。遺伝子型に基づく同定法は、より正確な種の同定を可能にし、可変的な表現型の問題を克服しました。一方、我々の結果は、(17,20,21)によって報告されたものと一致しており、L. plantarum株は、一次スクリーニングの寒天スポットテストと二次スクリーニングのウェル拡散法の両方で特定の病原体の増殖を阻害できることを示しています。分離株によって生成されたバクテリオシンは、2つの指標分離株に対して広範囲の活性を示したため、本研究で使用するために選択されました。さらに、抗菌剤としてのプロバイオティクスの重要性を研究する中で、研究では抗がん特性にも焦点を当てました。例えば、Lactobacillus株などの一部のプロバイオティクスは、肝臓がん、乳がん、胃がん、膀胱がん、結腸がんなどのがん細胞株の増殖を阻害することがわかりました。 MTT 試験では、分離された L. plantarum とそのバクテリオシンは食道がんに対して細胞毒性を示したが、正常細胞株 (線維芽細胞 REF) には影響を及ぼさないことが示され、この結果は (19、22) で報告されたものと一致している。 |
| 一方、本研究では、L.plantarumとバクテリオシンは、細胞の増殖速度を測定するMTT増殖アッセイにより、低濃度のIC50値で食道がん細胞株の増殖を著しく阻害することを示した。生成されたフォルマザンと生存細胞数の間には直線関係があることが実証された。このアプローチは、黄色のテトラゾリウムを青色のフォルマザンに変換する細胞の能力に基づいており、これは(19)に対応し、食道がん細胞株の時間依存増殖特性は、L.plantarumとバクテリオシンそれぞれ51.01CFU/mlと281.9AU/mlに相当し、(23)と一致している。食道がん細胞株をL.plantarumとバクテリオシンで処理すると、コントロール群と比較して増殖速度が大幅に低下した。さらに、治療期間後の細胞株における非生存細胞の割合が増加しました。 |
| しかし、食道がん細胞株におけるL. plantarumとバクテリオシンのMTT細胞毒性結果は、蛍光顕微鏡を使用した形態学的研究によってさらに裏付けられています。アクリジンオレンジ/プロピジウムヨウ化物染色アッセイとカスパーゼ-3が使用されました。アポトーシスの特徴が確認され、蛍光顕微鏡下でアポトーシスの割合が決定されました。アポトーシス細胞の計算は、細胞の総数の割合として説明されます。アポトーシス細胞の割合は、L. plantarumとバクテリオシンで処理されたアポトーシス細胞の割合が時間の経過とともに増加することを示しており、DNA染料で染色することによる細胞の変化によってアポトーシスを測定します(24)。膜透過性の変化によるアポトーシスは、生細胞と比較して生体染色色素であるアクリジンオレンジ / ヨウ化プロピジウムの取り込みの増加を示しました(23、24)。我々の結果は、L. plantarum で処理した 食道がん細胞株ではコントロール食道がんと比較してカスパーゼ 3 の発現が有意に高く (それぞれ p = 0.1、p = 0.8)、L. plantarum で処理した正常細胞株ではコントロール正常細胞と比較してカスパーゼ 3 の発現が有意に高かった (それぞれ p = 1.15、p = 0.9) ということである。結果は、バクテリオシンで処理したがん細胞株と未処理のコントロールとの間に有意差があることを示した (それぞれ p = 0.25、p = 0.80)。バクテリオシンで処理した正常細胞株と未処理のコントロールとの間に有意差はなかった (それぞれ p = 0.98、p = 0.9)。さらに、アポトーシスはアクリジンオレンジ (AO) とヨウ化プロピジウム(PI) 染色を使用して評価され、L. plantarum 処理した細胞のうち 78.4% がアポトーシスを起こし、79.18% が生存していることが示されました。さらに、食道がんでは、(図 11) に示す 食道がん細胞株をバクテリオシンで処理したところ、同等のアポトーシス細胞 (57.3%) が処理され、同等の生存細胞 (61.43%) が処理されました。言及した明確な形態学的特徴は、アポトーシスを識別および測定するために一般的に使用される最も基本的な方法の基礎となっています。その結果、顕微鏡検査と蛍光顕微鏡検査は、今でもアポトーシスを定義するための最良かつ効果的な方法の 1 つと考えられています (25)。これらの技術は、アポトーシスの量を正確に推定するために価値があり、これらの結果は報告されたものと一致しています (22、25)。そのため、アポトーシスの評価はカスパーゼ 3 活性アッセイを使用して行われます。カスパーゼ 3 の活性化は、細胞アポトーシスの中心的なリンクおよび実行者でした (26、27)。 |
| 特に、L. plantarum はいくつかの一般的な病原体に対して効果的なバクテリオシンを生産する能力を示したため、この種はいくつかの一般的な病原体やがん治療に適用できるバクテリオシン生産者として選択できます。L. plantarum とバクテリオシンは、正常な哺乳類細胞に対する細胞毒性が低く、特異的にアポトーシスを誘導し、がん治療のためにアポトーシス細胞を分解するため、有望な抗がん活性を持つ代替療法としての可能性を秘めています。 |
| この研究では、L. plantarum とそのバクテリオシンがE.coliと P. aeroginusa に対して効果的な抗菌活性を持つことが示されました。さらに、L. plantarum とそのバクテリオシンは、直接的な細胞毒性とアポトーシス効果によって 食道がん細胞株で細胞死を引き起こすことができ、正常細胞に対する毒性が低いことから選択性と高い安全性が示唆されています。これらの知見は、L. plantarum やそのバクテリオシンなどのプロバイオティクスを、食道がんに対する代替がん治療薬として臨床的に将来使用することを裏付けています。さらに、この研究では、抗がん作用のメカニズムと細菌とがん細胞の相互作用を理解するために、さらなる実験調査を実施することを推奨しています。 |
参考文献(本文中の文献No.は原論文の文献No.と一致していますので、下記の論文名をクリックして、原論文に記載されている文献を参考にしてください) |
|
この文献は、Int J Mol Cell Med 2024;13(3):286-302.に掲載されたLactobacillus Plantarum and its Derived Bacteriocin Exhibits Potent Antitumor Activity against Esophageal Cancer Cells. を日本語に訳したものです。タイトルをクリックして原文を読むことが出来ます。 |


